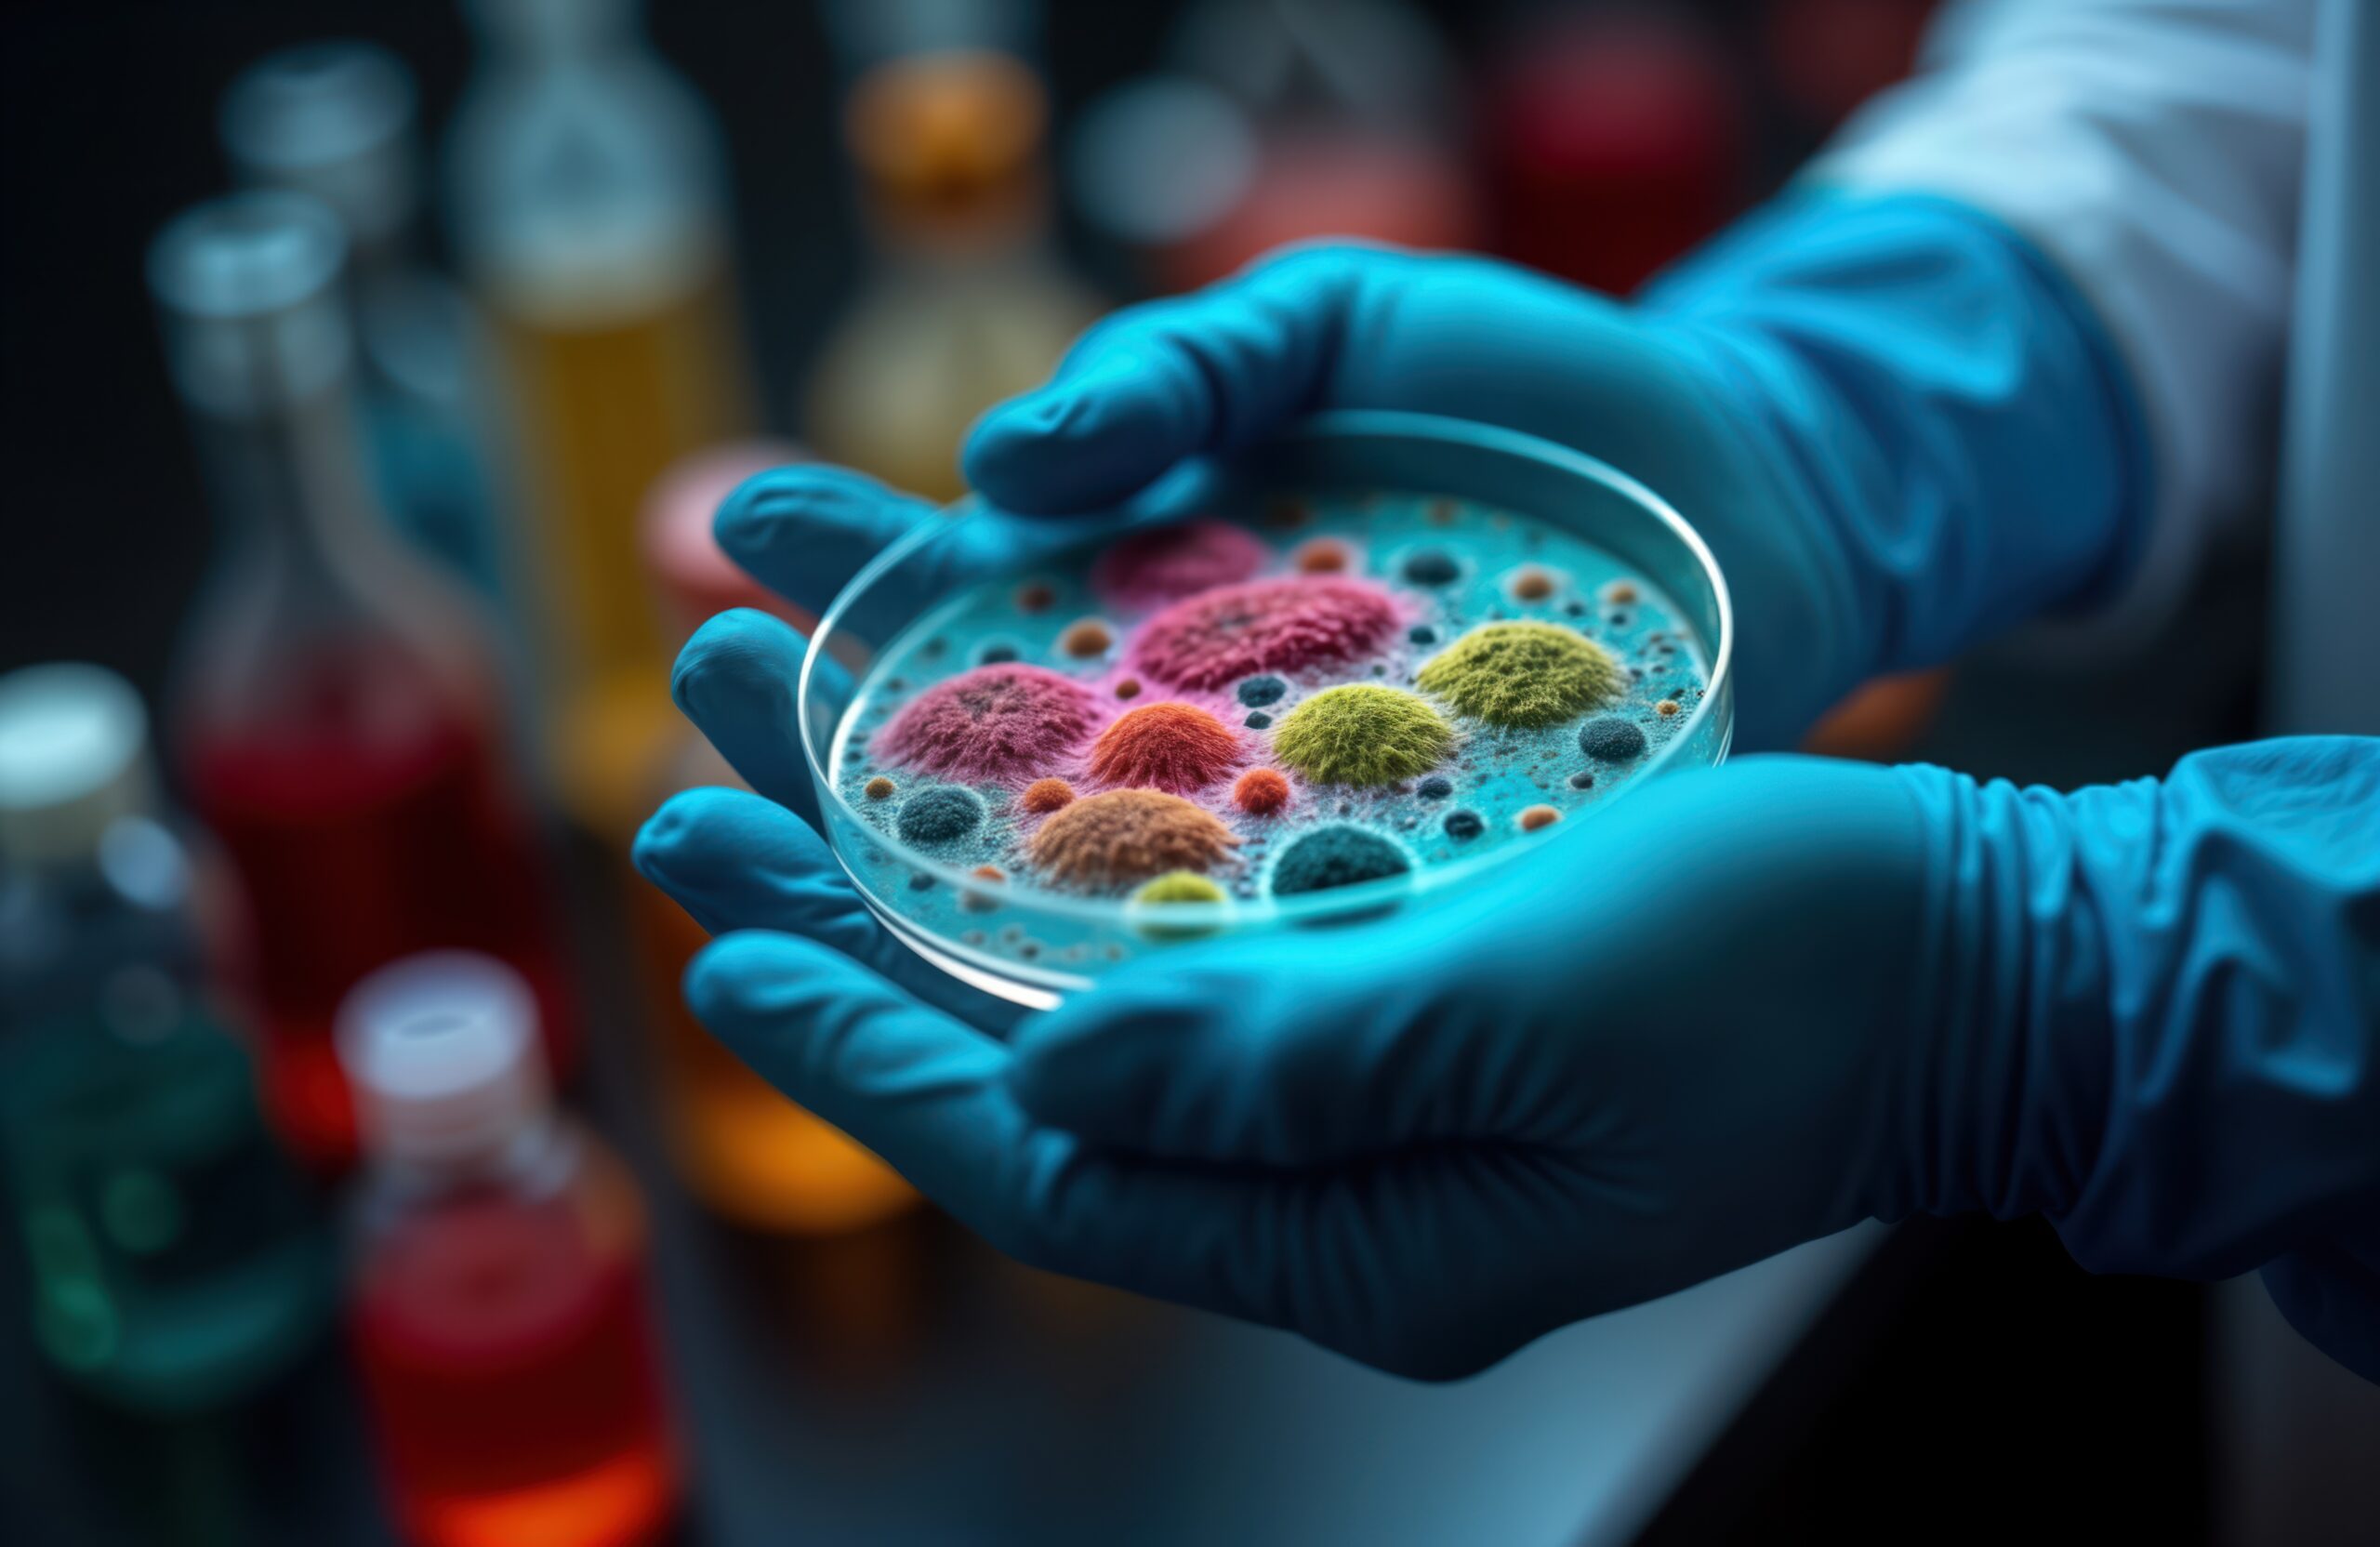
The Silent Battle Against Superbugs

A Race Against Time
Imagine waking up one morning with a fever and chills. You visit your doctor, who prescribes an antibiotic, just as they have many times before. But this time, something is different. Days pass, yet your condition worsens. The bacteria making you sick are resistant to the medication. The antibiotic meant to heal you no longer works. This is not a dystopian future; it is happening now.
Antimicrobial resistance (AMR) is a silent pandemic that threatens to return us to a pre-antibiotic era, where common infections could once again be fatal. The World Health Organization (WHO) has called AMR one of humanity’s top ten global public health threats. Despite efforts to combat this growing crisis, resistance rates continue to rise. The primary culprit? The misuse and overuse of antibiotics. However, there is another often-overlooked factor at play: diagnostics.
The Oxygen Analogy: Why AMR Matters Now
Think of antibiotics as oxygen in a space capsule. We have had an abundant supply for decades, but we are depleting it faster than it can be replenished. And yet, in the confined space of our healthcare system, someone keeps lighting matches—overprescription, incorrect antibiotic use, and a lack of diagnostic testing. If we do not act, we risk suffocating future generations under the weight of drug-resistant infections.
AMR is not just a medical issue but an economic and social crisis. By 2050, drug-resistant infections could cause up to 10 million deaths per year, surpassing cancer as the leading cause of mortality worldwide. The global economy could lose up to $100 trillion due to AMR-related costs. Without effective antibiotics, routine surgeries, cancer treatments, and even childbirth will become far riskier.
Diagnostics: The Unsung Hero in the Fight Against AMR
For decades, the focus has been on developing new antibiotics. While innovation in therapeutics is crucial, it only addresses one side of the equation. Without proper diagnostics, we are guessing which infections require treatment, leading to unnecessary prescriptions that accelerate resistance.
Diagnostics provide a roadmap for treatment. They determine whether an infection is bacterial or viral, guide the selection of the most effective antibiotic, and monitor patient response. Despite this, diagnostics remain underutilized. The lack of awareness, limited accessibility, and outdated perceptions of cost-effectiveness have hindered their adoption in clinical practice.
The technology already exists. Rapid molecular diagnostics can detect infections within hours rather than days. Artificial intelligence-driven diagnostics can analyze resistance patterns and predict the most effective treatments. Point-of-care tests make diagnostics accessible even in resource-limited settings. Yet, these tools are not widely used enough to make the necessary impact.
The Key Players in AMR Diagnostics
Several companies and institutions are in charge of integrating diagnostics into AMR solutions. bioMérieux, a global leader in in vitro diagnostics, has dedicated a significant portion of its R&D to AMR-related solutions. Their aim of being a guardian to establish a comprehensive antimicrobial stewardship framework that emphasizes diagnostics at every stage of care is happening now. Similarly, BD (Becton Dickinson) has developed automated microbiology solutions to accelerate bacterial identification and antibiotic susceptibility testing. Cepheid’s rapid molecular tests enable near-patient decision-making, reducing the delay in effective treatment.
Innovators such as Accelerate Diagnostics, T2 Biosystems, and Roche Diagnostics are also making strides. Accelerate Diagnostics focuses on rapid phenotypic antimicrobial susceptibility testing, dramatically cutting the time needed to determine resistance profiles. T2 Biosystems’ direct-from-blood diagnostics identify bloodstream infections without culture, a game-changer in critical care settings. Roche Diagnostics continues to expand its portfolio of PCR-based tests to enhance rapid bacterial detection.
Despite these advancements, adoption remains slow. Hospitals and clinics often cite cost as a barrier, yet the long-term benefits—shorter hospital stays, reduced unnecessary prescriptions, and fewer treatment failures—far outweigh the initial investment. Policymakers must recognize diagnostics as essential to AMR stewardship and prioritize funding and reimbursement structures that facilitate their use.
The Human Cost of AMR: A Story of Survival
Consider the story of Maria, a 42-year-old mother from Brazil. She developed a simple urinary tract infection, something that should have been easily treatable. However, the first antibiotic didn’t work. Nor did the second. After weeks of suffering, Maria was admitted to the hospital with sepsis. The bacteria in her body had evolved resistance to nearly all available antibiotics. Thanks to a last-resort diagnostic test, doctors finally identified a targeted treatment, saving her life. Maria’s story is a cautionary tale that underscores the urgency of integrating diagnostics into routine healthcare.
A Turning Point: Global Efforts to Prioritize Diagnostics
Governments and international organizations are beginning to acknowledge the vital role of diagnostics in AMR control. The European Union’s AMR action plan emphasizes better diagnostic utilization to optimize antibiotic prescribing. The PASTEUR Act seeks to incentivize antimicrobial innovation in the United States while promoting diagnostics to guide appropriate use. Low- and middle-income countries are also making strides, with organizations like the Fleming Fund supporting diagnostic capacity-building in regions with high AMR burdens.
However, more needs to be done. Public-private partnerships are essential to bridge the gap between innovation and implementation. Investment in AI-driven diagnostic systems, integration of big data analytics, and regulatory frameworks that encourage rapid diagnostics must become priorities.
The Future of AMR Diagnostics: What Comes Next?
The fight against AMR requires a paradigm shift. Diagnostics should no longer be an afterthought in infection management but the first step in determining whether antibiotics are needed. Artificial intelligence, machine learning, and genomic sequencing will revolutionize the field, making precision diagnostics more accessible and cost-effective. Governments must align policies to promote early diagnostic use. Healthcare systems must integrate these tools into routine care, and education efforts must ensure that doctors and patients understand the importance of diagnostic-led treatment.
If we do not act, AMR will define the next great global health crisis. But with the right tools, strategies, and commitment, we can turn the tide. We are racing to preserve one of our most significant medical advancements. The match is lit, and the oxygen is running low. The time for action is now.